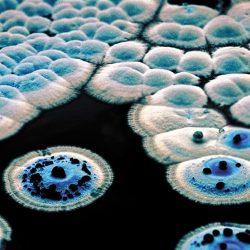
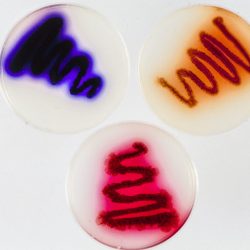
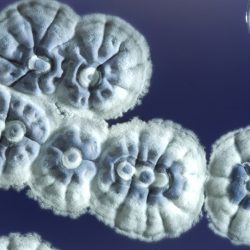
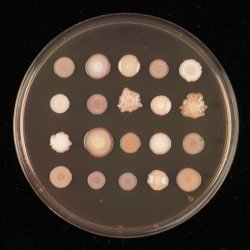

What is microbial science?
Microbial science or Microbiology is the study of microorganisms, a diverse group of generally tiny life-forms that include bacteria, fungi, viruses, archaea, algae, and protozoa.
We may not be able to see them with the naked eye, but they are all around us, inside and out. In fact, microbial life is the most dominant form of life on earth, with the American Academy of Microbiology suggesting that:
“There are ten-million-fold more bacterial and archaeal cells on our small planet than there are stars in the visible universe, and they may contain as much carbon as all plant and animal life put together”
Microbial research investigates the structure, function, and classification of these organisms, because understanding the fundamentals of these minute forms of life, and the environments they inhabit can provide valuable insights both scientifically and to society as a whole.
Microbiology is a key field for the search for new medicines and novel strategies for preserving plant health by providing environmentally friendly solutions to a changing climate.
The early days of Fungal research at John Innes
While the John Innes Centre enjoys a global reputation as a plant science institute, we also have an incredible microbial research community here. This dates back to the very first years of the Institute, when Dorothy Cayley arrived as a volunteer worker in 1910 and began working on fungal pathogens in peas and fruit, becoming our first mycologist.
Years later, in the 1950s our microbial genetics programme starts to take shape, building on the work of Peter Day, who worked on Fulvia fulva (Cladosporium fulvum), the cause of leaf mould disease, a problem which was plaguing commercial tomato growers.
Continued research into fungal genetics was bolstered by the arrival of John Fincham as the new Head of Genetics in 1960. Fincham was a specialist on the bread mould Neurospora crassa and his appointment established the Institute as a serious player in the developing field of microbial genetics.
Fincham’s colleagues Dan Lewis and Robin Holliday would shape the course of microbial science, both here and around the world. While working on DNA damage and genetic recombination in Ustilago maydis (corn smut) and the yeast Saccharomyces cerevisiae, Holliday published a model of DNA-strand exchange to try and explain the major features of crossing-over, gene conversion, and post-meiotic segregation that had been documented in several fungi. His simple model incorporated the cross-stranded (or cruciform) DNA structure that later became known as the ‘Holliday Junction’ (a mobile junction between four strands of DNA). Holliday’s junction became a cornerstone of recombination models.
Bacterial Research begins
Work on the genetics of plant viruses started at the John Innes Centre, when we moved to Norwich in 1967 and were joined by the Virus Research Unit.
Three years earlier, we also began to research bacteria at the John Innes Centre, kicked off by the appointment of Sir David Hopwood in July 1968. Initially Hopwood worked alone and supervision was minimal. He has since suggested the approach was; ‘here are Streptomyces, they may be intermediate life forms, see you in two years’s time’, meaning Hopwood’s research into Streptomyces, Rhixobium and Agrobacterium tumefaciens was initially to determine whether Streptomyces was a fungus or bacteria and was controversial at a ‘plant science’ institute, but the new antibiotics the work uncovered rapidly converted sceptics.
The story of Sir David’s life and work was published in a biography in 2017
Modern Microbial Research
Streptomyces has proven a vital source of antibiotics and now over 60% of clinical antibiotics are produced by actinomycetes, a long, thin bacteria, commonly found in soil and associated with plants.
Following in the footsteps of Sir David, Dr Andy Truman leads a group at the John Innes Centre dedicated to exploring how these complex molecules are produced and exploiting their properties, while Professor Barrie Wilkinson researches the discovery and biosynthesis of microbial natural products, hoping to identify new compounds with antibiotic and antifungal properties.
Professor George Lomonossoff’s group continues to investigate viruses. The group have found that through exploring their structure and properties, it is possible to create Virus Like Particles (VLPs) which have the shape of the virus without containing the genetic material which causes infection and allows them to reproduce.
These particles stimulate an immune response in humans so can be used as safe vaccines. Using agrobacteria to transfer the genes responsible for expressing these particles into leaves they have made it possible to use plants to manufacture VLPs and aim to produce vaccines quicker and more cheaply with this technology.
A candidate polio vaccine has been produced using this method, and spin out company Leaf Expression Systems is also using this method to revolutionise the manufacture of a range of other molecules.
While some microbes are beneficial, some can be harmful to human or plant health. Another area of our research is to observe the proliferation and characterise the structure of microbes, such as Pseudomonas which Dr Jacob Malone is researching to establish which of Pseudomonas’ characteristics are important for its agriculturally beneficial interactions in soil, in the hope of developing new ways to deal with their potentially disastrous impact.
We are also part of a new consortium exploring a bacterium, Xylella fastidiosa which infects a wide range of plants.
This insect-transmitted bacterial plant pathogen infects 500 species including crops, ornamental plants, and trees. In Italy alone, over 1 million olive trees are dying from Xylella in a disease called Olive Quick Decline Syndrome. If the bacteria spreads to the UK it could have a devastating impact on agriculture.
Work continues into two harmful fungi which have already made it to Britain; Ash-dieback and Fusarium head blight and wheat blast which affects cereal crops.
Working together
Of course, we can’t do any of this work alone and we work closely with a variety of collaborators.
We are proud to be part of the ‘Microbes in Norwich’ (MICRON) partnership; which joins all of us on the Norwich Research Park together encompassing scientists and projects at the University of East Anglia, The Sainsbury Laboratory, the Quadram Institute, the Earlham Institute, the Norfolk and Norwich University Hospital and of course ourselves, making Norwich the UK’s leading site for microbiology research.